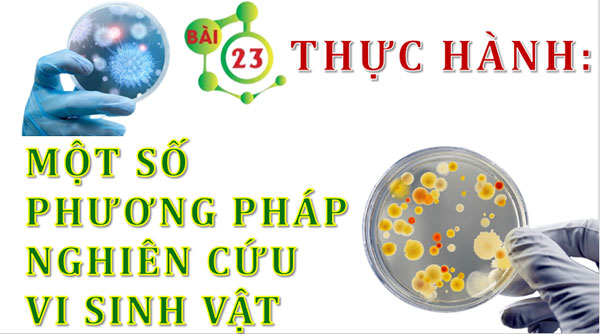

Đóng
Chỉ thành viên Hoatieu Pro tải được nội dung này!
Hoatieu Pro - Tải nhanh, website không quảng cáo!
Tìm hiểu thêm
Mua Hoatieu Pro 99.000đ
Bạn đã mua gói? Đăng nhập ngay!
Bài viết hay Giáo án lớp 10
-
PowerPoint Hóa 10 Bài 3: Nguyên tố hóa học
-
PowerPoint Địa lí 10 Bài 29: Địa lí một số ngành công nghiệp
-
PowerPoint Chuyên đề Vật lí 10 Bài 8: Tác động của việc sử dụng năng lượng hiện nay đối với Việt Nam
-
Giáo án Powerpoint Toán 10 Cánh Diều Học kì 2
-
PowerPoint Hóa 10 Bài 8: Quy tắc oclet
-
Giáo án Powerpoint Địa lí 10 Kết nối tri thức Học kì 2